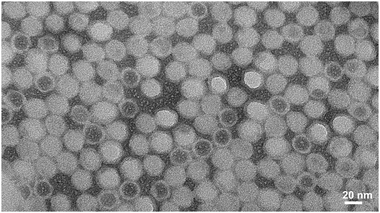
Unstained TEM image of CoPt-CPMV mineralized particles.

DOI:
10.1039/C0IB00056F
(Paper)
Integr. Biol., 2011,
3, 119-125
Received
21st June 2010
, Accepted 30th September 2010
First published on 28th October 2010
Abstract
The external surface of the plant virus Cowpea mosaic virus (CPMV) can be chemically modified with peptides that direct specific mineralization processes. Subsequent mineralization of the peptide-CPMV conjugates produces monodisperse nanoparticles of ca. 32 nm diameter coated with, for example, cobalt–platinum, iron–platinum or zinc sulfide, which cannot be readily prepared by other methods. This route is particularly attractive as it avoids the need to genetically engineer the protein surface of the virus to provide chimaeras for templated-mineralization. The synthetic procedure is environmentally friendly, as it proceeds at ambient temperature and pressure, in aqueous solvent. Further, the methodology is demonstrated to be generally applicable by the mineralization of a peptide-modified multiwalled carbon nanotube.
Insight, innovation, integration
Synthetic biology incorporates as one of its themes the re-design of existing, natural biological systems for new uses and purposes. Here, a naturally occurring nanoparticle, the plant Cowpea mosaic virus of ca. 28 nm diameter, is chemically engineered to display peptides on the external surface of the capsid that promote specific mineralization processes. Subsequent mineralization of the modified particles provides a new and general route to monodisperse metal nanoparticles that can not be readily obtained by other means. The particles have the potential for a wide range of applications in, for example, nanomaterials and devices, catalysis and biomedicine.
|
Introduction
The preparation of nanoparticles with controlled size and composition is of major fundamental and technological interest.1 For example, mixed-metal nanoparticles, such as those of FePt and CoPt, have been identified as important materials for use in catalysis and in ultra-high density magnetic storage devices,2 and semiconducting zinc sulfide nanoparticles promise applications in a range of optoelectronic devices, such as solar cells.3,4 To be useful, the size and size distribution of the nanoparticle needs to be controlled.5,6 Further, hollow nanospheres may have many applications in, for example, catalysis, where a hollow nanosphere has a higher catalytically active surface area than its solid analogue and also consumes less of the costly and limited metal resources in its synthesis.7
The exploitation of biomaterials for chemical design, an avenue of synthetic biology, has become an important area of materials science.8 For example, bacteriophages and plant viruses provide a variety of morphologies and are robust enough to support reactions to produce new organic and inorganic materials.9–12 The bacteriophage M13 can template mineralization12 and has been utilised in, for example, the development of lithium ion battery electrodes,13 the exterior and interior of the rod-shaped plant virus Tobacco mosaic virus10,14 as well as the interior cavities of the icosahedral, sphere-like, Cowpea chlorotic mottle virus11,15 and empty (RNA-devoid) virus-like particle of Cowpea mosaic virus (CPMV)16 can be used for the controlled entrapment and mineralization of materials. Furthermore, the exploitation of peptide-based methods for the fabrication of nanostructured inorganic materials has been developed.17
Whereas the interior cavity of sphere-like virus particles had been previously exploited for mineralization,11,15,16,18 it was only recently that we reported controlled nucleation and deposition of inorganic materials on the exterior surface of such bionanoparticles.19,20 CPMV particles have the characteristics of an ideal nanotemplate in terms of their size (∼28 nm diameter) and their regular symmetric structure. The structure of the virus particle is known to near atomic resolution and its genetic, biological and physical properties are well characterised.21 Functional groups on the exterior surface of the virion makes CPMV a useful nanoscaffold allowing attachment of a multitude of different moieties.22 Furthermore, infectious cDNA clones and chimaeric virus technology can be used to modify the surface and allow the presentation of foreign peptides on the particle surface.23 The observation that certain peptide sequences can stimulate the deposition of specific inorganic compounds12,24,25 led us to demonstrate that CPMV-based chimaeric virus technology could be adapted for the environmentally benign synthesis of virus-templated monodisperse silica19 and iron–platinum20 nanoparticles.
However, preparation of CPMV-based chimaeras requires genetic modification of the CPMV coat protein. The subsequent expression, propagation, isolation and purification of the chimaera are lengthy and the yields can be low, especially in cases where the insert is not well tolerated.26 Also, there can be problems with chimaera stability and there is the potential for reversion to wild-type, as we have found for a chimaera with a peptide insert that would promote mineralization with CoPt. In some cases, the appropriate chimaera cannot be produced at all, for example that which includes the peptide to direct mineralization with ZnS. We show here that, rather than by genetic modification, the appropriate peptide to promote mineralization with, for example, CoPt, FePt or ZnS respectively, can be easily chemically coupled to amino acid residues on the surface of wild-type CPMV (that can be obtained in yields of 1 g per kg of infected leaf material). The peptide-CPMV conjugate can then template the directed and controlled fabrication of monodisperse nanoparticles, of approximately 32 nm diameter, at ambient temperature and pressure in aqueous solvent (Scheme 1). We also show, by the peptide-promoted mineralization of a multiwall carbon nanotube (MWCNT), that the method is generally applicable to any suitable modifiable surface.
 |
| | Scheme 1 | |
Experimental
Materials
The N-protected peptides Carboxybenzyl (Cbz)-CNAGDHANC, Cbz-CNAHDGANC, Cbz-HNKHLPSTQPLA and Cbz-CNNPMHQNC were purchased from GeneCust, Luxembourg. All general reagents were brought from Sigma-Aldrich UK and used without further purification. 1-ethyl-3-(3-dimethlyaminopropyl)carbodiimide hydrochloride (EDC) was purchased from Novabiochem and N-hydroxysuccinimide (NHS) from Fluka. Amine-functionalised short, thin, multiwall carbon nanotubes (MWCNT), 95% C purity, with average diameter of 9.5 nm and average length of 1 μm were supplied by Nanocyl S.A., Belgium.
Cowpea mosaic virus (CPMV)
The propagation and purification of wild-type CPMV particles were performed by standard procedures.27 Purified virions were stored at 4 °C in 10 mM sodium phosphate buffer pH 7.0. The concentration of purified virions was determined photometrically; the molar extinction coefficient of CPMV at a wavelength of λ = 260 nm is ε = 8.1 mL mg−1 cm−1.
General method for chemical coupling of peptide to CPMV
The carboxylic acid terminus of peptide was activated by the carbodiimide method using EDC and NHS. Cbz-peptide in Milli-Q water (Millipore) was incubated with a freshly prepared Milli-Q water solution of EDC (1 molar equivalent) for 5 min followed by the addition of a freshly prepared dimethylsulfoxide (DMSO) solution of NHS (4 molar equivalents). The reaction was allowed to proceed for 2 h at room temperature with gentle stirring. The activated peptide was then added to a solution of CPMV in 10 mM sodium phosphate buffer pH 7.0 in a molar ratio of 2000
:
1, the reaction was incubated at 4 °C overnight with gentle stirring. The resultant peptide-CPMV conjugate was purified by gel filtration (AKTA Purifier-900) on a Sephacryl S-500 column (GE Healthcare). Fractions containing only the peptide-CPMV conjugate were pooled, concentrated using 100 kDa cut-off membranes (Millipore), and analysed by native agarose gel electrophoresis and transmission electron microscopy (TEM) to ensure the presence and integrity of the modified CPMV particles. The peptide-CPMV conjugate concentration was determined by UV-visible spectrophotometry; the yield of peptide-CPMV conjugate was between 70–90% based on the initial virus concentration.
Preparation of mineralized virus nanoparticles
To peptide-CPMV (400 μL of 10 mg/mL) in 10 mM sodium phosphate buffer pH 7.0 was added, with constant stirring, over 10 min at room temperature either: (a) a 1
:
1
:
1 mixture of CoCl2 (0.05 mol dm−3), H2PtCl6 (0.05 mol dm−3) and NaBH4 (0.1 mol dm−3) each in Milli-Q water (400 μL); (b) a 1
:
1
:
1 mixture of FeCl3 (0.05 mol dm−3), H2PtCl6 (0.05 mol dm−3) and NaBH4 (0.1 mol dm−3) each in Milli-Q water (400 μL); or (c) a 1
:
1 mixture of ZnCl2 (0.05 mol dm−3) and Na2S (0.05 mol dm−3) each in Milli-Q water (400 μL). The mixture was incubated, with gentle stirring at ambient temperature, for 40–48 h. The FePt-CPMV, CoPt-CPMV and ZnS-CPMV nanoparticles, respectively, were recovered by centrifugation at 14
000 rpm (bench top, Eppendorf) for 20 min. The supernatant containing the mineralized-CPMV nanoparticles was further purified using 100 kDa cut-off columns and washed several times with Milli-Q water to remove all excess reagents. The yield of nanoparticles was 70–80% as determined by UV-visible spectrophotometry based on the initial virus concentration. The method can be scaled up at least two-and-a-half fold; at larger scales a combination of dialysis (100 kDa membrane) and sucrose gradient (2.1 mL 10–50% sucrose gradients centrifuged at 137
000 g for 1.5 h at 4 °C; 175 μL fractions containing mineralized particles were collected and dialysed against 10 mM sodium phosphate buffer pH 7.0 for 15 h) was used to purify the particles. The integrity, characterisation and composition of the mineralized-CPMV nanoparticles were determined by TEM, energy dispersive X-ray spectroscopy (EDXS), nanoparticle tracking analysis (NTA), dynamic light scattering (DLS) and zeta potential measurements. The number of peptides per particle was determined for peptideCoPt-CPMV conjugate as follows. PeptideCoPt-CPMV in sodium phosphate buffer pH 7 was reacted with a 2000 molar excess of NHS ester-activated amine specific dye, DyLight594, in DMSO. The DMSO level was adjusted to 20% v/v and the reaction left to proceed at 4 °C overnight while gently stirring. The doubly functionalised particles were purified on a PD-10 column equilibrated with 10 mM sodium phosphate buffer pH 7.0, and eluted samples were concentrated on 100 kDa cut-off columns before being layered onto 5 mL 10%–50% sucrose gradients. The gradients were centrifuged at 137
000 g for 1 to 1.5 h at 4 °C; 300 μL fractions were collected and dialysed against 10 mM sodium phosphate buffer pH 7.0 for 2 days. After further concentration on 100 kDa cut-off columns, the number of free reactive lysines was calculated, from the absorbance spectrum (ESI‡), to be ∼66 per virion. This equates to approximately 180 peptides {maximum addressable amines (240) − free amines remaining in conjugate (66) = 174} being bound to each CPMV virus particle.
External surface mineralization of amine-functionalised MWCNT
Cbz-CNAGDHANC (peptideCoPt; 1.0 mg/mL) was activated with a freshly prepared solution of EDC (1 molar equivalent) in Milli-Q water for 5 min followed by the addition of a freshly prepared DMSO solution of NHS (4 molar equivalents). The reaction was allowed to proceed for 2 h at room temperature with gentle stirring. The solution of activated-peptideCoPt was added to a suspension of amine surface-functionalised, short, thin, multi-wall carbon nanotubes (MWCNT; 0.30 mg) in Milli-Q water (1 mL) and then gently stirred at 4 °C overnight. The resultant peptide-functionalised MWCNT (MWCNTpeptide) was purified on a 100 kDa cut-off column. A suspension of MWCNTpeptide (100 μL) was treated with a 1
:
1
:
1 mixture of CoCl2 (0.05 mol dm−3), H2PtCl6 (0.05 mol dm−3) and NaBH4 (0.1 mol dm−3) each in Milli-Q water (500 μL). The reaction was allowed to proceed at ambient temperature with gentle stirring. After 24 h the reaction mixture was centrifuged at 14
000 rpm (bench top) for 10 min, the pellet was re-suspended in Milli-Q water and purified further on a 100 kDa cut-off column and washed thoroughly with Milli-Q water. TEM examination showed partial mineralization of the nanotube external surface. The process described above was repeated over seven days to give external surface-mineralized MWCNT.
Characterisation methods
UV-visible spectra were recorded on a Perkin Elmer Lambda 25 spectrometer using UVWINLab software. TEM images were obtained on a FEI Tecnai 20 TEM, FEI UK Ltd, Cambridge, using carbon-coated copper EM grids (400 mesh, Agar Scientific). An Oxford Instruments INCA Energy 200Premium was used for EDXS and a NanoSight LM 10 instrument for NTA (ca. 80 micron wide 640 nm wavelength laser beam; cell depth 0.5 mm; cell volume ca. 0.25 mL. Samples for NTA were prepared with 300 μL (0.2–0.5 mg mL−1) of mineralized-CPMV particles suspended in 10 mM sodium phosphate buffer pH 7.0 and analysed by recording a 30 s video of the nanoparticles' motion when illuminated by laser light mounted under the microscope objective lens. The particles movement was tracked using conventional CCD camera, operating at 30 frames per second. DLS was measured on a DynaPro Titan, Wyatt Technology Corporation (laser wavelength 830 nm, scattering angle 20°), and zeta potential on a Malvern Instruments Zetasizer-Nano ZS. For scanning electron microscopy (SEM), FePt-CPMV particles were air dried on a freshly prepared mica surface. The mica was mounted on an aluminium pin stub using double-sided adhesive carbon discs (Agar Scientific Ltd) and the stub was then sputter-coated with approximately 10–15 nm platinum in a high-resolution sputter coater (Agar Scientific Ltd). The coated stub was transferred to a Zeiss Supra 55 VP FEG scanning electron microscope (Zeiss SMT) and the samples were viewed at 3 kV with an in-lens detector.
For immunological detection of CPMV coat proteins, 10 μg each of wild-type CPMV, CoPt-CPMV, FePt-CPMV and ZnS-CPMV, in 10 mM phosphate buffer, were spotted onto a nitrocellulose membrane (Amersham) and air dried for 30 min. Nonspecific binding sites were blocked using a solution consisting of 5% skim-milk powder in phosphate buffered saline (PBS) plus 0.025% (v/v) Tween-20. The membrane was then probed with a polyclonal antibody specific to CPMV (G49) followed by a horseradish peroxidise-conjugated anti-rabbit antibody. Both antibodies were diluted in blocking solution. Signals were generated by chemiluminescence using SuperSignal West Dura substrate kit (Thermo Scientific) and captured on film (HyperfilmTM ECL, Amersham Biosciences) which was developed using a Curix 60 film processor (Agfa Gevaert). Sodium dodecyl sulfate polyacrylamide gel electrophoresis (SDS-PAGE) was performed on 5–10 μg of virus in 10 mM sodium phosphate buffer pH 7.0 mixed with 3 μL of 4× RunBlue LDS Sample Buffer (Expedeon), samples were heated for 5–10 min at 100 °C in a thermoblock in order to denature the protein. In the case of the mineralized particles, they were heated for 20 min with 10% sodium dodecyl sulfate. The samples were analysed on 12% TEO-CI SDS RunBlue precast gels (Expedeon) under non-reducing conditions at 180 V for 30–70 min using 600–700 mL of 20
:
1 dilution of 20× RunBlue SDS Running Buffer (Expedeon). The bands when stained with 20 mL of InstantBlue (Expedeon) were visible after a few minutes. Gels were washed with Milli-Q water prior to imaging.
Results and discussion
Peptide-CPMV conjugates
Peptides previously identified through an evolutionary screening process, using phage display technologies, that specifically direct mineralization by CoPt (CNAGDHANC; peptideCoPt), FePt (HNKHLPSTQPLA; peptideFePt) and ZnS (CNNPMHQNC; peptideZnS) were selected.12 The carboxybenzyl (Cbz) amine-terminus protected peptides were purchased from a commercial supplier. To prepare peptide-CPMV conjugates, the carboxyl-terminus of the relevant peptide was first pre-activated by conversion to the O-succinimide active ester. Reaction of the peptide ester with surface amines, derived from lysine groups exposed on the external surface of wild-type CPMV, generated peptide-CPMV conjugates in 70–90% recovered yield based on the initial virus concentration. The integrity of the modified particles was confirmed by TEM (not shown) and agarose gel electrophoresis. Fig. 1 shows an ethidium bromide stained agarose gel of wild-type, a positive control of O-succinimide esterified CPMV and three peptide-CPMV conjugates. According to their migration in an electric field towards the anode, intact virions of wild-type CPMV can be separated into a higher- and lower-mobility form, depending on their RNA content. The O-succinimide esterified CPMV particles migrate more slowly toward the anode than wild-type and each of the three peptide-CPMV conjugates, which all show a similar mobility. The number of peptides per virion was estimated to be 180 based on the reaction of an amine specific dye with the remaining unreacted lysine residues after conjugation of peptide. The peptide-CPMV conjugates were found to be monodisperse by DLS and the particle size did not increase significantly compared to wild-type.
 |
| | Fig. 1 Agarose gel (1.2%) of CPMV particles visualised by ethidium bromide staining. M represents a 1 kbp DNA ladder. Lane 1, wild-type CPMV; 2, EDC/NHS-activated CPMV; 3, peptideCoPt-CPMV;4, peptideFePt-CPMV; 5, peptideZnS-CPMV. | |
Reaction of peptide-CPMV conjugates with reagents for mineralization produced monodisperse nanoparticles. For example, treatment of peptideCoPt-CPMV in buffer with an equimolar mixture of cobalt(II)chloride and hexachloroplatinic acid together with two molar equivalents of sodium borohydride reductant produced, within 48 h, virus-templated CoPt-CPMV particles. A similar approach was used to prepare FePt-CPMV nanoparticles. For ZnS-CPMV, the reagents used were zinc chloride and sodium sulfide in an equimolar ratio. After purification, the mineralized particles were obtained in 70–80% recovered yield based on the initial virus concentration. This protocol requires neither high temperature nor pressure and is performed in aqueous buffer and produces little waste so is environmentally benign. We have found that it can be readily scaled-up to 10 mg mL−1 of virus particles. The peptide-CPMV conjugates are specific to their corresponding mineralization process. Wild-type CPMV, when incubated under identical conditions with the reagents for mineralization, was unaffected; no monodisperse, templated nanoparticles were formed but some non-specific mineralization was observed. Similarly, the peptide alone does not promote formation of monodisperse nanoparticles. When the conjugate that is specific for directed CoPt mineralization, peptideCoPt-CPMV, was reacted with the reagents for mineralization with FePt or ZnS, and vice versa, there was no evidence for templated-mineralization. In the case of peptideCoPt-CPMV, we found that mineralization occurs irrespective of the C- to N-terminus ordering of the peptide; that is, peptide can be bound by the C-terminus carboxylate to amine groups on the virus surface as Cbz-CNAGDHANC or Cbz-CNAHDGANC without the mineralization process being affected.
The unstained TEM images for CoPt-CPMV, FePt-CPMV and ZnS-CPMV are shown in Fig. 2–4, respectively, and reveal dense, monodisperse, mineralized nanoparticles of ca. 32 nm. Wild-type CPMV when treated under identical mineralization conditions and after purification cannot be visualised in an unstained TEM image and can only be seen after negative staining with uranyl acetate. These images are similar to those previously observed for templated mineralized-CPMV particles prepared using CPMV-chimaeras20 and confirm that the peptide-CPMV conjugates direct templated surface mineralization. EDXS (ESI‡) confirmed that cobalt and platinum, iron and platinum, and zinc and sulfur coated the external surfaces of CoPt-, FePt- and ZnS-CPMV nanoparticles, respectively. Two distinct morphologies could be seen in the unstained TEM image of CoPt-CPMV (Fig. 2). One is as expected for an externally mineralized virus capsid but the other, with a darker core, is similar to that observed for internally-mineralized CPMV empty (devoid of RNA) virus-like particles (eVLPS) in which the internal cavity contains metal.16 During a normal plant infection with wild-type CPMV, up to 10% of the virions isolated are devoid of RNA. It is proposed that the particles exhibiting the darker core are naturally occurring eVLPs that have been mineralized, in this case, both externally and internally. Mineralization of naturally occurring eVLPs that have been chemically modified to display peptideCoPt on their outer surface showed a similar morphology in the TEM (ESI‡), supporting this hypothesis. Agarose gel electrophoresis (Fig. 1) can not differentiate between the two morphologies, as the eVLPs that are both externally and internally mineralized do not contain encapsidated RNA, which would stain with ethidium bromide. Further, agarose gel electrophoresis (see ESI‡) of CoPt-CPMV stained with ethidium bromide shows some fluorescent intensity from a band of different mobility to wild-type and to peptideCoPt-CPMV conjugate, suggesting that the CoPt-CPMV surface has some limited porosity sufficient to allow intercalation of ethidium bromide with the encapsulated RNA. For FePt-CPMV and ZnS-CPMV no significant fluorescence is observed implying that there is no surface porosity after mineralization. When the gel is stained with Coomassie blue no colouration is observed for each of the mineralized samples, this is consistent with the virus protein surface not being accessible to the stain as it is coated with mineral. In addition, the CPMV coat protein of CoPt-CPMV, FePt-CPMV and ZnS-CPMV was not detected immunologically. Wild-type CPMV and samples of each of the mineralized particles were spotted onto a nitrocellulose membrane which, after blocking, was probed with polyclonal antibodies raised in rabbits against CPMV particles. The binding of the antibodies was detected using a goat anti-rabbit IgG coupled to horseradish peroxidise and the signals were visualised by chemiluminescence (Fig. 5). Only in the case of wild-type CPMV was a signal obtained, confirming the presence of CPMV coat protein; for the mineralized particles the coat protein was not accessible to the antibody presumably due to the mineral coating. Further support for the deposition of a robust mineral shell on the external surface is provided by comparison of the SDS-PAGE of mineralized and non-mineralized CPMV particles (Fig. 6). Even under harsh denaturing conditions, such as with sodium dodecyl sulfate at 100 °C for 20 min, there is only very partial release of coat proteins on denaturation of the mineralized-CPMV particles as shown by the near absence of coat proteins on the SDS-PAGE gel. This is what would be expected if the denaturing agent either is unable to penetrate the mineral coat and/or the coat proteins cannot be released from the mineralized shells.
|
| | Fig. 2 Unstained TEM image of CoPt-CPMV mineralized particles. | |
 |
| | Fig. 3 Unstained TEM image of FePt-CPMV mineralized particles. | |
 |
| | Fig. 4 Unstained TEM image of ZnS-CPMV particles. | |
 |
| | Fig. 6 SDS-PAGE. Lane 1, wild-type CPMV; 2, peptideCoPt-CPMV; 3, CoPt-CPMV; 4, peptideFePt-CPMV; 5, FePt-CPMV; 6, peptideZnS-CPMV; 7, ZnS-CPMV. | |
The results of DLS and zeta potential measurements for the mineralized nanoparticles are shown in Table 1 (and see ESI‡). The particle size in buffer as measured by DLS shows an increase in average hydrodynamic diameter to ca. 32 nm following mineralization. Prior to peptide-modification and mineralization, CPMV has a diameter of ca. 28 nm, implying that the coating on each particle is approximately 2 nm. This contrasts with a coating of 1 nm observed when FePt is templated on chimaeric CPMVFePt.20 The coating thickness is significantly greater than the ionic diameter of individual metal atoms (0.15–0.19 nm) and the length of the coupled-peptide (ca. 1.00–1.50 nm). The DLS polydispersity indicates that, by this criterion and in agreement with the observed TEM images, the particles are monodisperse and that the coated CPMV particles are uniformly mineralized on their outer surfaces. The zeta potential for suspensions of the mineralized particles in buffer are considerably more negative than that for wild-type CPMV, of ca. −12 mV, and show that the colloids have good stability and no propensity to aggregate. NTA (Fig. 7), based on laser light scattering microscopy, was also consistent with mineralization of the virus. For each of the mineralized virus particles there was a significant increase in the relative refractive index compared with wild-type and with peptide-CPMV conjugates. The analysis is also consistent with the mineralized particles being monodisperse as indicated by the particle size distribution; although for ZnS-CPMV there was a little non-specific aggregation under the measurement conditions employed. The scanning electron micrograph of FePt-CPMV (Fig. 8) provides further evidence that the templated nanoparticles retain their integrity and monodispersity.
 |
| | Fig. 7 Negative image of a freeze-frame from nanoparticle tracking analysis for mineralized-CPMV nanoparticles showing that the particles appear individually as point scatterers under Brownian motion with a high refractive index. (A) CoPt-CPMV; (B) FePt-CPMV; (C) ZnS-CPMV. | |
 |
| | Fig. 8 SEM image of sputter-coated FePt-CPMV deposited on a mica surface. | |
| |
DLS diameter (nm) |
Polydispersity (%) |
Zeta potential (mV) |
| CPMV |
27.4 ± 0.5 |
14.0 |
−12.3 ± 1.5 |
| CoPt-CPMV |
31.8 ± 0.5 |
16.7 |
−39.1 ± 2.1 |
| FePt-CPMV |
32.0 ± 0.2 |
20.9 |
−60.3 ± 1.9 |
| ZnS-CPMV |
30.8 ± 0.4 |
15.0 |
−22.2 ± 3.3 |
To demonstrate that the chemically-coupled-peptide-promoted method of mineralization is a general method for any suitably modified surface we used this approach to coat a MWCNT with CoPt. PeptideCoPt can be easily coupled to an amine surface-functionalised MWCNT (Fig. 9A) by the standard protocol to give the peptide-modified MWCNTpeptide. Incubation of MWCNTpeptide with cobalt chloride, hexachloroplatinic acid and sodium borohydride reductant followed by purification after 24 h shows, by TEM, the initiation of mineralization (Fig. 9B) at, presumably, the sites of peptide coupling. This process is analogous to that which occurs on mineralization of peptide-CPMV conjugates (vide supra). Repeating the mineralization process sequentially over seven days produced a thick, ca. 20 nm, fairly uniform coating, of CoPt (Fig. 9C) as confirmed by EDXS (ESI‡).
 |
| | Fig. 9 Peptide-promoted mineralization of amine-functionalised MWCNT. (A) Amine-functionalised MWCNT; (B) PeptideCoPt-modified MWCNT after 24 h mineralization showing initial nucleation sites of CoPt; (C) CoPt-mineralized MWCNT after seven days treatment. | |
Conclusion
Chemically-coupled-peptide-promoted mineralization of wild-type CPMV provides an efficient route to monodisperse, spherical nanoparticles of ca. 32 nm, which cannot readily be obtained by other techniques. The method is relatively simple and does not require genetic engineering of the virus surface, which can be problematic due to, for example, instability of the virus chimaeras including their reversion to wild-type in planta. The preparation of the peptide-CPMV conjugates and their subsequent mineralization is environmentally benign. Further, templated nanoparticles require less (precious) metal for their formation compared to solid nanoparticles of the same surface area. The mineralized-CPMV nanoparticles are robust and stable and show little propensity to aggregate. Chemically-coupled-peptide-promoted mineralization is a general route, as we have demonstrated with MWCNTs; genetic fusion can only be performed on a biological entity whereas, in principle, the chemical approach can be followed with anything that can be functionalised. We are currently investigating the chemical and physical properties of these and other mineralized-CPMV nanoparticles and how they may be utilised for potential applications in new nanomaterials and devices, catalysis and biomedicine.
Acknowledgements
This work was supported by the Biotechnology and Biological Sciences Research Council, UK [Core Strategic Grant to the John Innes Centre, G.P.L. and D.J.E., JIC DTG, A.A.A.A. and grant number BB/E024939/1, S.N.S.]. J. Elaine Barclay, Kim Findlay and Sue Bunnewell (JIC), and Mike Ridout and Andrew Kirby (Institute of Food Research, Norwich) are thanked for technical assistance.
References
- S. Sun, C. B. Murray, D. Weller, L. Folks and A. Moser, Science, 2000, 287, 1989–1992 CrossRef CAS.
- T. Hyeon, Chem. Commun., 2003, 927–934 RSC.
- X. D. Gao, X. M. Li and W. D. Yu, Thin Solid Films, 2004, 468, 43–47 CrossRef CAS.
- R. Chen and D. Lockwood, J. Electrochem. Soc., 2002, 149, S69–S78 CrossRef CAS.
- S. Sun, Adv. Mater., 2006, 18, 393–403 CrossRef CAS.
- J. Nanda, S. Sapra, D. D. Sarma, N. Chandrasekharan and G. Hodes, Chem. Mater., 2000, 12, 1018–1024 CrossRef CAS.
- H.-P. Liang, H.-M. Zhang, J.-S. Hu, Y.-G. Guo, L.-J. Wan and C.-L. Bai, Angew. Chem., Int. Ed., 2004, 43, 1540–1543 CrossRef CAS.
- D. J. Evans, J. Mater. Chem., 2008, 18, 3746–3754 RSC; M. Uchida, M. T. Klem, M. Allen, P. Suci, M. Flenniken, E. Gillitzer, Z. Varpness, L. O. Liepold, M. Young and T. Douglas, Adv. Mater., 2007, 19, 1025–1042 CrossRef CAS; E. Dujardin and S. Mann, Adv. Eng. Mater., 2002, 4, 413–417.
- C. E. Flynn, S.-W. Lee, B. R. Peelle and A. M. Belcher, Acta Mater., 2003, 51, 5867–80 CrossRef CAS; S. R. Hall, H. Bolger and S. Mann, Chem. Commun., 2003, 2784–85 RSC;
Nanobiotechnology: Concepts, Applications and Perspectives, ed. C. M. Niemeyer and C. A. Mirkin, Wiley-VCH Verlag, Weinheim, Germany, 2004 Search PubMed.
- C. E. Fowler, W. Shenton, G. Stubbs and S. Mann, Adv. Mater., 2001, 13, 1266–69 CrossRef CAS; W. Shenton, T. Douglas, M. Young, G. Stubbs and S. Mann, Adv. Mater., 1999, 11, 253–256 CrossRef CAS.
- T. Douglas and M. Young, Nature, 1998, 393, 152–55 CrossRef CAS.
- C. Mao, D. J. Solis, B. D. Reiss, S. T. Kottmann, R. Y. Sweeney, A. Hayhurst, G. Georgiou, B. Iverson and A. M. Belcher, Science, 2004, 303, 213–7 CrossRef CAS; B. D. Reiss, C. Mao, D. J. Solis, K. S. Ryan, T. Thomson and A. M. Belcher, Nano Lett., 2004, 4, 1127–1132 CrossRef CAS.
- K. T. Nam, D.-W. Kim, P. J. Yoo, C.-Y. Chiang, N. Meethong, P. T. Hammond, Y.-M. Chiang and A. M. Belcher, Science, 2006, 312, 885–888 CrossRef CAS.
- S. Balci, A. M. Bittner, K. Hahn, C. Scheu, M. Knez, A. Kadri, C. Wege, H. Jeske and K. Kern, Electrochim. Acta, 2006, 51, 6251–6357 CrossRef CAS; E. Dujardin, C. Peet, G. Stubbs, J. N. Culver and S. Mann, Nano Lett., 2003, 3, 413–417 CrossRef CAS; M. Knez, A. M. Bittner, F. Boes, C. Wege, H. Jeske, E. Maiß and K. Kern, Nano Lett., 2003, 3, 1079–1082 CrossRef CAS; M. Knez, A. Kadri, C. Wege, U. Gosele, H. Jeske and K. Nielsch, Nano Lett., 2006, 6, 1172–1177 CrossRef CAS; M. Knez, M. Sumser, A. M. Bittner, C. Wege, H. Jeske, S. Kooi, M. Burghard and K. Kern, J. Electroanal. Chem., 2002, 522, 70–74 CrossRef CAS; M. Knez, M. Sumser, A. M. Bittner, C. Wege, H. Jeske, T. P. Martin and K. Kern, Adv. Funct. Mater., 2004, 14, 116–124 CrossRef CAS; S. Y. Lee, J. Choi, E. Royston, D. B. Janes, J. N. Culver and M. T. Harris, J. Nanosci. Nanotechnol., 2006, 6, 974–981 CrossRef CAS; S. Y. Lee, E. Royston, J. N. Culver and M. T. Harris, Nanotechnology, 2005, 16, S435–441 CrossRef; E. Royston, S. Y. Lee, J. N. Culver and M. T. Harris, J. Colloid Interface Sci., 2006, 298, 706–712 CrossRef CAS; S. Fujikawa and T. Kunitake, Langmuir, 2003, 19, 6545–6552 CrossRef CAS.
- T. Douglas and M. Young, Adv. Mater., 1999, 11, 679–681 CrossRef CAS; T. Douglas, E. Strable, D. Willits, A. Aitouchen, M. Libera and M. Young, Adv. Mater., 2002, 14, 415–418 CrossRef CAS; M. T. Klem, M. Young and T. Douglas, J. Mater. Chem., 2008, 18, 3821–3823 RSC; A. de la Escosura, M. Verwegen, F. D. Sikkema, M. Comellas-Aragones, A. Kirilyuk, T. Raising, R. J. M. Nolte and J. J. L. M. Cornelissen, Chem. Commun., 2008, 1542–1544 RSC.
- A. A. A. Aljabali, F. Sainsbury, G. P. Lomonossoff and D. J. Evans, Small, 2010, 6, 818–821 CrossRef CAS.
- C.-L. Chen and N. L. Rosi, Angew. Chem., Int. Ed., 2010, 49, 1924–1942 CAS.
- L. Loo, R. H. Guenther, S. A. Lommel and S. Franzen, J. Am. Chem. Soc., 2007, 129, 11111–11117 CrossRef CAS; X. Huang, L. M. Bronstein, J. Retrum, C. Dufort, I. Tsvetkova, S. Aniagyei, B. Stein, G. Stucky, B. McKenna, N. Remmes, D. Baxter, C. C. Kao and B. Dragnea, Nano Lett., 2007, 7, 2407–2416 CrossRef CAS.
- N. F. Steinmetz, S. N. Shah, J. E. Barclay, G. Rallapalli, G. P. Lomonossoff and D. J. Evans, Small, 2009, 5, 813–816 CrossRef CAS.
- S. N. Shah, N. F. Steinmetz, A. A. A. Aljabali, G. P. Lomonossoff and D. J. Evans, Dalton Trans., 2009, 8479–8480 RSC.
- G. P. Lomonossoff and J. E. Johnson, Prog. Biophys. Mol. Biol., 1991, 55, 107–137 CrossRef CAS; T. Lin and J. E. Johnson, Adv. Virus Res., 2003, 62, 167–239 CAS.
- N. F. Steinmetz and D. J. Evans, Org. Biomol. Chem., 2007, 5, 2891–2902 RSC; D. J. Evans, Inorg. Chim. Acta, 2010, 363, 1070–1076 CrossRef CAS.
- J. T. Dessens and G. P. Lomonossoff, J. Gen. Virol., 1993, 74, 889–92 Search PubMed; G. P. Lomonossoff and J. E. Johnson, Curr. Opin. Struct. Biol., 1996, 6, 176–182 CrossRef CAS; T. Lin, C. Porta, G. P. Lomonossoff and J. E Johnson, Folding
Des., 1996, 1, 179–187 CrossRef CAS; K. M. Taylor, T. Lin, C. Porta, A. G. Mosser, H. A. Giesing, G. P. Lomonossoff and J. E. Johnson, J. Mol. Recognit., 2000, 13, 71–82 CrossRef CAS; A. Chatterji, L. L. Burns, S. S. Taylor, G. P. Lomonossoff, J. E. Johnson, T. Lin and C. Porta, Intervirology, 2002, 45, 362–370 CrossRef CAS.
- M. Sarikaya, C. Tamerler, D. T. Schwartz and F. Baneyx, Annu. Rev. Mater. Res., 2004, 34, 373–408 CrossRef CAS.
- N. Kröger, R. Deutzmann and M. Sumper, Science, 1999, 286, 1129–1132 CrossRef CAS; R. R. Naik, L. L. Brott, S. J. Clarson and M. O. Stone, J. Nanosci. Nanotechnol., 2002, 2, 95–100 CrossRef CAS; C. Mao, C. E. Flynn, A. Hayhurst, R. Sweeney, J. Qi, G. Georgiou, B. Iverson and A. M. Belcher, Proc. Natl. Acad. Sci. U. S. A., 2003, 100, 6946–6951 CrossRef CAS; R. M. Kramer, C. Li, D. C. Carter, M. O. Stone and R. R. Naik, J. Am. Chem. Soc., 2004, 126, 13282–13286 CrossRef CAS; M. T. Klem, D. Willits, D. J. Solis, A. M. Belcher, M. Young and T. Douglas, Adv. Funct. Mater., 2005, 15, 1489–1494 CrossRef CAS.
- C. Porta, V. E. Spall, K. C. Findlay, R. C. Gergerich, C. E. Farrance and G. P. Lomonossoff, Virology, 2003, 310, 50–63 CrossRef CAS.
- J. Wellink, Methods Mol. Biol., 1998, 81, 205–209 CAS.
Footnotes |
| † Published as part of an iBiology themed issue on Synthetic Biology: Guest Editor Professor John McCarthy. |
| ‡ Electronic supplementary information (ESI) available: Quantification of peptides bound to surface lysines in peptideCoPt-CPMV, energy dispersive X-ray spectroscopy, mineralization of peptideCoPt-modified empty CPMV particles, agarose gel electrophoresis, dynamic light scattering and zeta potential measurements. See DOI: 10.1039/c0ib00056f |
| § Present address: CIC 03, Self Assembly Group, CIC nanoGUNE, Tolosa Hiribidea, 76, E-20018, Donostia-San Sebastian, Spain. |
|
| This journal is © The Royal Society of Chemistry 2011 |
Click here to see how this site uses Cookies. View our privacy policy here.